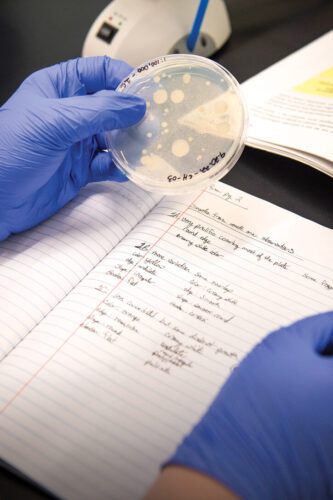
Student inspecting sample in a petrie dish, taking notes.

Linfield students are looking for the next life-saving antibiotic in the tiniest places

Anne-Julienne Arnholtz ’26 walked through the densely wooded forest, crossing streams and getting her Converse stuck in the muddy riverbed. She and Linfield classmate Lauren Hendrickson ’25 had driven 25 miles northwest of McMinnville, into the Siuslaw National Forest, not to enjoy the expansive views of lush evergreen trees or the changing colors of the season, but to look down at the nutrient-rich
dirt beneath their feet.
It wasn’t just any soil they were looking for; they were searching for a very specific patch of dirt, full of microbial activity.
“We’re looking for naturally diverse samples, and if you want natural diversity, you don’t want a place that is highly cultivated,” Hendrickson said. “This is the ‘wildest’ I can get around here!”
Arnholtz and Hendrickson, students in Linfield’s Principles of Biology class, were gathering soil samples for a project called Tiny Earth. The initiative works with students from campuses across the globe to crowd-source soil bacteria in the hopes of discovering new and desperately needed antibiotics.
“We as a society are in the midst of an antibiotic crisis,” said Jeremy Weisz, Linfield associate professor of biology and instructor for the Principles of Biology class. “The rate at which individual antibiotics are becoming useless is much greater than the rate at which we are discovering new antibiotics. This might not sound like a big deal, but imagine if you had strep throat or got an infected cut on your leg and we had no drug to treat you. People regularly died from minor wounds prior to the discovery of antibiotics, and we as a society are headed back toward those conditions.”
The World Health Organization (WHO) agrees. A 2017 report titled “Antibacterial agents in clinical development – an analysis of the antibacterial clinical development pipeline, including tuberculosis” warns of a “serious lack of new antibiotics under development to combat the growing threat of antimicrobial resistance.”

Finding solutions with Tiny Earth
Created by Jo Handelsman, who serves as the Vilas Research Professor of Plant Pathology at the University of Wisconsin-Madison, Tiny Earth hopes to inspire and retain students in the sciences while addressing the global challenge of antibiotic resistance.
Students participating in the program collect soil samples and learn how to extract bacteria from the sample. After a few weeks of microbial growth, students analyze the petri dishes for signs that the bacteria in the soil could be used to create a new antibiotic. Samples with possible activity are sent for additional genomic and metabolic testing to the Tiny Earth headquarters at UW-Madison. This “student-sourcing” allows the researchers to obtain and analyze viable samples quickly.

“Tiny Earth seeks to speed up the discovery of new antibiotics,” Weisz said.
The program was formed out of a microbiology course Handelsman taught at Yale University in 2012. By 2018, the class had grown into a low-cost curriculum and instructor training program, available to science programs throughout the world. Today, there are 51 institutions with more than 700 instructors and 14,000 students participating in Tiny Earth.
“It’s exciting to watch the Tiny Earth Network grow and expand,” she said. “I am awed and humbled by how the network runs on the power of … volunteers who seem to have boundless energy and good will to improve the curriculum and help students and other instructors.”
A process of discovery
Weisz started using the Tiny Earth curriculum at Linfield in 2014, making it the first school in Oregon to participate.
The Principles of Biology class is a popular course, but due to space issues, the class has only been held once per year. However, the new W.M. Keck Science Center includes additional classroom and lab space that will allow the introductory class to be offered each semester, giving more Linfield undergraduates the chance to participate.
Although he would, of course, love for a Linfield student to discover a new lifesaving antibiotic, Weisz knows the value of Tiny Earth lies in the hands-on scientific research that students are doing in an introductory-level course.
“Science is about discovery, I want all of our students to have the opportunity to discover something new.”
– Jeremy Weisz, associate professor of biology
Even though Weisz has been leading the program for eight years, in 2021 was the first time a Linfield student found enough microbial activity to send on for further analysis. Amazingly, it was not just a single sample – but seven!
Arnholtz hopes her samples from the Siuslaw National Forest – nicknamed “Hershey” and “Tzatziki” – continue this trend.
“I started reading about the shortage of antibiotics and how the science community has slowly been stopping research into antibiotics, knowing that there are antibiotic-resistant strains that are tougher and harder and meaner out there that are constantly evolving,” Hendrickson said.
“Being part of any progress in the field of antibiotics would be exciting!”
